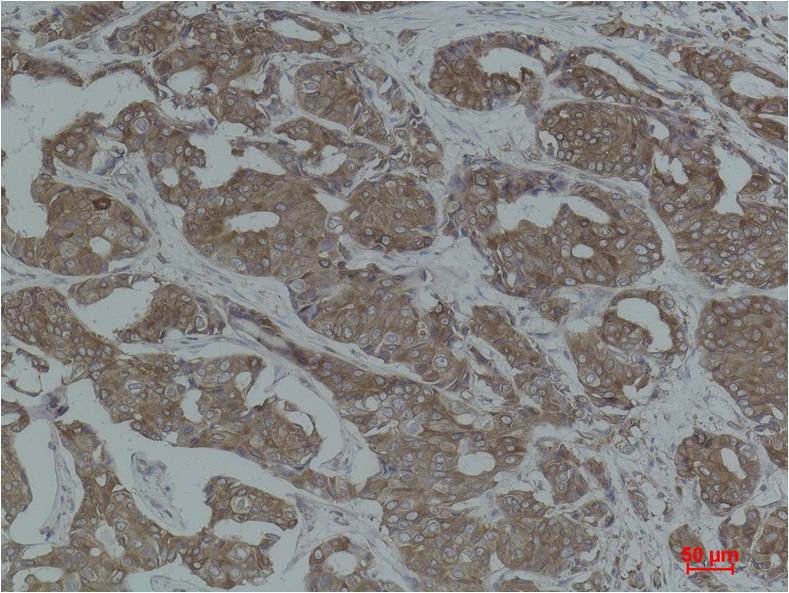

Calnexin Rabbit pAb
 One-click to copy product information
One-click to copy product information$148.00/50µL $248.00/100µL
| 50 µL | $148.00 |
| 100 µL | $248.00 |
Overview
| Product name: | Calnexin Rabbit pAb |
| Reactivity: | Human, Rat, Mouse |
| Alternative Names: | CANX antibody, CNX antibody, FLJ26570 antibody, IP90 antibody, P90 antibody |
| Source: | Rabbit |
| Dilutions: | WB 1:1,000-2,000 IHC 1:200-500 |
| Immunogen: | Recombinant Protein |
| Storage: | PBS with 0.02% sodium azide and 50% glycerol pH 7.4. Store at -20°C. Avoid repeated freeze-thaw cycles. |
| Clonality: | Polyclonal |
| Isotype: | IgG |
| Concentration: | 1mg/mL |
| Observed Band: | 75,80,90kDa |
| GeneID: | 821 |
| Human Swiss-Prot No: | P27824 |
| Cellular localization: | Endoplasmic reticulum membrane,Melanosome. |
| Background: | Calnexin is a chaperone, characterized by assisting protein folding and quality control, ensuring that only properly folded and assembled proteins proceed further along the secretory pathway. Calnexin is a integral protein (that appears variously as a 90kDa, 80kDa or 75kDa band on western blotting depending on the source of the antibody) of the endoplasmic reticulum (ER). It consists of a large (50 kDa) N-terminal calcium-binding lumenal domain, a single transmembrane helix and a short (90 residues), acidic cytoplasmic tail. |

 Manual
Manual